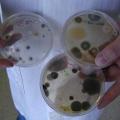
Mold Inspection & Testing DC

Washington, DC Home Services

Mack Chimney Services
E Capitol St NE,
Washington, 20019
202-597-0064
Established in 1983, the team at Mack Chimney Services are here to provide our clients with cost effective masonry work. With over 20 years of quality industry experience, our company has a lifetime of knowledge about our services and the overall ...
View detail page - Mack Chimney Services

Washington DC Pest Control
1629 K St NW Suite 300,
Washington, 20006
202-499-7642
We are a pest control company in Washington DC. Our exterminators provide a full range of services including termite inspections, bed bug extermination, ant, roach, and rodent services (mice, snakes, rats, moles etc).
View detail page - Washington DC Pest Control

Auto Locksmith
3033 New Mexico Ave NW,
Washington, 20016
202-688-0466
So, why are we the best auto lock and car keys service? To sum up:
We are the most affordable locksmith service for vehicles (don't waste your money!)
We are available 24/7 (even when the others aren't)
Our team of car locksmith ...
View detail page - Auto Locksmith

EvensonBest
1000 Vermont Avenue NW,
Washington, 20005
202-540-5700
"Dealing with substandard office furniture can be a real pain; no one knows this better than the business furniture experts from EvensonBest. With three locations in Washington DC, New Jersey and New York, they're considered one of the ...
View detail page - EvensonBest

AIR DUCT CLEANING DC
5644, 3rd Street NE,
Washington, 20011
202-459-0998
Find the best Air duct cleaning in Washington DC.
The air that your breathe inside your house definitely has its impact in your daily living. Your family and your kids will most certainly be affected by the air. Usually, the air you breathe ...
View detail page - AIR DUCT CLEANING DC

ABC Cleaning
Washington,
Washington, 20002
202-204-6191
We are a certified company, both insured and bonded, with an excellent staff. Our customers know that if you want the best company for cleaning, restoration and home improvement you can count on us.
Flood Damage, Residential Remodeling Services, ...
View detail page - ABC Cleaning

Presto Pest Control Inc
.,
Washington, 20015
202-866-6038
Presto Pest Control is a commercial pest control company that services primarily the food service, hospitality and building management industries. Our company is extremely aggressive in providing the ultimate service in commercial pest control. ...
View detail page - Presto Pest Control Inc

DC Maids Cleaning service.
1025 Connecticut Ave NW suite 1000,
Washington, 20036
202-459-0972
DC MAIDS CLEANING SOLUTIONS.We try to make the world a Clean place to live.Affordable Carpet Cleaning, Same Day Cleaning Services, Retainer Service, Residential Cleaning.
View detail page - DC Maids Cleaning service.
Mold Inspection & Testing DC
1666 32nd St NW,
Washington, 20007
202-650-0254
Mold Inspection & Testing DC is a mold inspector proudly serving the Washington DC area. Since 2009, the company has built a sterling reputation for quality and accuracy across the city. The goal of Mold Inspection & Testing DC is to give ...
View detail page - Mold Inspection & Testing DC

EZ Bed Bug Exterminator Washington DC
700 7th St SE,
Washington, 20003
202-816-4033
If you're in Washington DC and seeking a bed bug extermination team that guarantees you get rid of those bed bugs - CALL US NOW.. Our process will make sure those bugs are removed! Call us now if you want to be bed bug free - we guarantee ...
View detail page - EZ Bed Bug Exterminator Washington DC

Washington Appliance Repair Van
3412 Wisconsin Ave NW,
Washington, 20016
202-607-2930
At Washington Appliance Repair Van, we are a complete appliance repair company that has been in business for many years. We are recognized for providing outstanding services at very affordable prices. Excellent customer service and is our number ...
View detail page - Washington Appliance Repair Van

Washington Appliance Repair Solutions
218 Cedar St NW,
Washington, 20012
202-601-0662
At Washington Appliance Repair Solutions, we are a complete appliance repair company that has been in business for many years. We are recognized for providing outstanding services at very affordable prices. Excellent customer service and is our ...
View detail page - Washington Appliance Repair Solutions

Washington 24/7 Appliance Repair
4300 Military Rd NW,
Washington, 20015
202-601-0661
At Washington 24/7 Appliance Repair, we are a complete appliance repair company that has been in business for many years. We are recognized for providing outstanding services at very affordable prices. Excellent customer service and is our number ...
View detail page - Washington 24/7 Appliance Repair

Washington Appliance Repair Van
3412 Wisconsin Ave NW,
Washington, 20016
202-607-2930
At Washington Appliance Repair Van, we are a complete appliance repair company that has been in business for many years. We are recognized for providing outstanding services at very affordable prices. Excellent customer service and is our number ...
View detail page - Washington Appliance Repair Van

Washington Appliance Repair Solutions
218 Cedar St NW,
Washington, 20012
202-601-0662
At Washington Appliance Repair Solutions, we are a complete appliance repair company that has been in business for many years. We are recognized for providing outstanding services at very affordable prices. Excellent customer service and is our ...
View detail page - Washington Appliance Repair Solutions

Discount Appliance Repair DC
3328 19th Street Northwest,
Washington, 20010
202-280-1687
Our DC based Appliance Repair company is specialized in providing scheduled regular maintenance for all your appliances or conduct any emergency appliance repair. Our technicians have all the experience, knowledge and tools that are needed in order ...
View detail page - Discount Appliance Repair DC

DC Handyman
1025 Connecticut Ave NW,
Washington, 20036
202-380-0993
DC Handyman Service / Home Repair Services.
Visit: handymandistrictofcolumbia . com
View detail page - DC Handyman

Handyman Of DC 1
.,
Washington, 20019
202-796-2792
"You Only Need To Make One Call - No Job Too Big Or Too Small." Handyman Of DC 1 is a Handyman located in Washington, DC and have been servicing all of Washington and the surrounding areas. We specialize in Dry Wall ...
View detail page - Handyman Of DC 1

Cheap Movers DC
3509 Connecticut Avenue NW #10028,
Washington, 20008
202-774-9296
Cheap Movers DC is the best mover in the nation's capital. We don't play politics and our business is simple. We offer great moving services at affordable prices. Moving shouldn't cost a fortune and it doesn't with Cheap Movers ...
View detail page - Cheap Movers DC

Bed Bug Exterminator Washington DC
2635 Connecticut Ave NW,
Washington, 20008
202-750-4066
If you're in Washington DC and seeking a bed bug extermination team that guarantees you get rid of those bed bugs - CALL US NOW.. Our process will make sure those bugs are removed! Call us now if you want to be bed bug free - we guarantee our ...
View detail page - Bed Bug Exterminator Washington DC

Washington DC Water Damage Pros
1150 4th Street SW,
Washington, 20024
703-935-0193
Washington DC Water Damage Pros is one of the top providers in Toronto area for water damage restoration. We take pride in our work and want our customers to be happy. We do the job right and restore your house or building back to the original state.
View detail page - Washington DC Water Damage Pros

Washington DC Restoration Experts
712 H Street NE #1085,
Washington, 20002
202-734-5265
Specialized fire, smoke, water and mold damage restoration, remediation and clean-up experts serving the greater Washington, DC metro area
View detail page - Washington DC Restoration Experts

Triple A A/C Service LLC
2032 N Capitol St Nw,
Washington, 20002
240-417-5632
As a full service HVAC provider, Triple A A/C Service LLC has been assisting the local Washington community consistently and effectively throughout the years. Whether you're looking for service, installation, or repair, you can rely on us. We ...
View detail page - Triple A A/C Service LLC

Washington DC Galaxy Locksmith
612 Division Avenue Northeast,
Washington, 20019
202-753-3884
"Washington DC Galaxy Locksmith has been servicing since 1994. It continues to provide the best Locksmith Services and products to help keep people safe and secure in Washington, DC. From Doors to Cars and from Home Safe installation to simple ...
View detail page - Washington DC Galaxy Locksmith

Washington DC Advantage Locksmith
1517 Connecticut Avenue Northwest,
Washington, 20036
202-753-3888
"Washington DC Advantage Locksmith in Washington, DC is a Locally based Locksmith Company, available also in the surrounding Areas. Our certified Locksmith Experts provide a wide range of Locks and Key Services, including Lost Key Replacement, ...
View detail page - Washington DC Advantage Locksmith

Washington DC Pro Locksmith
1100 4th St Sw Suite: 3,
Washington, 20024
202-753-3886
"Here at Washington DC Pro Locksmith we push ourselves on making our customers happy by providing great Locksmith Services and for a reasonable price. We offer the best quality Locksmith service and trained professionals in Washington, DC ...
View detail page - Washington DC Pro Locksmith

Washington DC Emergency Locksmith
306 Southern Avenue Southeast,
Washington, 20032
202-753-3887
"Here at Washington DC Emergency Locksmith we are fully Bonded, Licensed and Insured. Our company provides Affordable and Professional Locksmith Service 24/7 all year long in Washington, DC Metro area. Our highly trained Locksmith technicians ...
View detail page - Washington DC Emergency Locksmith

Washington DC Elite Locksmith
4822 Yuma Street Northwest Suite: 6,
Washington, 20016
202-753-3881
"Washington DC Elite Locksmith 24 hours a day and seven days a week, and we are just a phone call away when you need a Reliable Locksmith. No matter what time of the day and what day of the week, we are available to help you with your ...
View detail page - Washington DC Elite Locksmith

Washington DC Express Locksmith
3124 12th Street Northeast Suite: 2,
Washington, 20017
202-753-3882
"Washington DC Express Locksmith is a full Service Locksmith and Hardware store in the heart of Washington, DC. We are a family owned business serving The Washington and the metro area for over 30 years and have always been committed to giving ...
View detail page - Washington DC Express Locksmith

Washington DC Locksmith Solution
314 Carroll Street Northwest Suite: B,
Washington, 20012
202-753-3744
"At Washington DC Locksmith Solution you can find professional Locksmith technicians that are License Bonded and Insured in the state of District of Columbia, We provide a 24 Hr Locksmith Service 7 days a week in all the area of Washington, ...
View detail page - Washington DC Locksmith Solution

Washington DC Neighborhood Locksmith
1810 K Street Northwest Suite: C6,
Washington, DC, 20006
202-753-3648
At Washington DC Neighborhood Locksmith we are proud to offer Locksmith Services in Washington, DC. If you are Locked Out of your home call our Locksmiths for Expert Lock and key Solutions. Like: Opening Locks, Lock Picking & Jammed Doors and ...
View detail page - Washington DC Neighborhood Locksmith

Washington DC Master Locksmith
5247 Wisconsin Avenue Northwest Suite: B,
Washington, 20015
202-753-3750
"At Washington DC Master Locksmith we are proud to offer Locksmith Services in Washington, DC. If you are Locked Out of your home call our Locksmiths for Expert Lock and key Solutions. Like: Opening Locks, Lock Picking & Jammed Doors and ...
View detail page - Washington DC Master Locksmith

Washington DC General Locksmith
222 7th Street Southeast Suite: D,
Washington, 20003
202-753-3645
Here at Washington DC General Locksmith we push ourselves on making our customers happy by providing great Locksmith Services and for a reasonable price. We offer the best quality Locksmith service and trained professionals in Washington, DC Metro ...
View detail page - Washington DC General Locksmith

Washington DC Expert Locksmith
1110 Vermont Avenue Northwest Suite: H,
Washington, 20005
202-753-3647
Our promise to you and this great community is the promise of great Emergency Locksmith Services in Washington, DC Metro area. We offer these 24 hours a day Locksmith Service For any needed give us a call at any time For your Locksmiths Needed. ...
View detail page - Washington DC Expert Locksmith

DC Glass Doors and Window Repair
1416 North Capitol St NW,
Washington, 20002
877-269-9869
Partner of Washington Glass LLC, we specialize in Glass repair, Glass replacement, Glass doors, Glass repairs, Shower doors, storm doors, tempered glass, laminated glass, window repair, glass shelves, glass table tops, skylights, door closers, ...
View detail page - DC Glass Doors and Window Repair

M & M Handyman Services
4501 Alabama Ave SE,
Washington, 20019
202-276-0900
M & M Handyman Services is a professional and pre-screened and seasoned handyman. We can do any jobs around your house including Screens - put up, take down, repair, masonry work, siding repairs, install blinds, Pet doors, Smoke detectors as ...
View detail page - M & M Handyman Services

M&M Home Repair
198 54th Street SE,
Washington, 20019
202-276-0900
M & M Home Repair is a professional and pre-screened and seasoned handymen. We can do any jobs around your house including Screens - Put up, take down, repair, masonry work, siding repairs, install blinds, Pet doors, Smoke detectors as well as ...
View detail page - M&M Home Repair

Tier4 Mattress
5720 Georgia Ave. NW,
Washington, 20011
844-210-4730
Tier4 Mattress is a mattress store in Washington, DC that offers name brand, luxury mattresses at a reduced price. The mattress store inventory includes name-brand, tier 4 luxury prices at an appealing discounted price.
View detail page - Tier4 Mattress

Washington DC Restoration Pros
1629 K St. NW, Suite 300,
Washington, 20006
202-798-7878
For your Emergency Water Damage Restoration needs all of our service repair technicians are fully licensed and insured. Washington DC Restoration Pros guarantees 100% customer satisfaction on all water damage restoration services. Residential Water ...
View detail page - Washington DC Restoration Pros

Bolt Locksmith
5335 Wisconsin Ave NW,
Washington, 20015
443-720-7566
Bolt Professional Locksmith Services Taking Care of Locksmith Problems in Washington D.C and Maryland
Security is one of the foremost concerns of everybody. For that, all kinds of security measures are often utilized by many people and the most ...
View detail page - Bolt Locksmith

Morrison Home Enterprises
4529 9th street nw,
Washington, 20011
202-644-9986
When you are in need of experienced and affordable Washington, DC General Contractors, call Morrison Home Enterprises. We take pride in our impeccable workmanship and will meet all your needs.
View detail page - Morrison Home Enterprises

ADT
Washington, DC,
Washington, 20006
202-734-6654
To get any more information about company call us anytime of day.
View detail page - ADT

Joel Truitt Builders, Inc
734 7th St SE,
Washington, 20003
202-547-2707
The Washington, DC design and build firm that has been providing high-quality home remodeling and restoration since 1972. Known for custom woodworking, doors, trim and cabinetry at rates competitive with stock items. Countertops, flooring, ...
View detail page - Joel Truitt Builders, Inc

KMF Enterprise, LLC
.,
Washington, 20002
202-710-4935
KMF Enterprise, LLC is a Cleaning Company located in Washington DC and has been servicing all of DC and the surrounding areas for many years. We specialize in Janitorial Services, House Cleaning , Commercial Cleaning, Residential Cleaning, Office ...
View detail page - KMF Enterprise, LLC

House Committee on Science, Space, and Technology
2321 Rayburn House Office Building,
Washington, 20515
202-225-6371
Information about the work of this committee of the US House of Representatives
View detail page - House Committee on Science, Space, and Technology

penguin renovations
V # 219 I St NE,
Washington, 20005
202-509-7739
Just tell us your needs, and we’ll satisfy them beyond your expectations. Penguin Renovations in Washington, DC, is so sure you’ll be 100% happy with your new floor, that we offer The Beautiful Guarantee. We like to develop strong relationships ...
View detail page - penguin renovations

Paul Corrie Interiors
1739 Kenyon Street NW,
Washington, 20010
202-234-0653
Paul Corrie Interiors is a boutique interior design firm located in Washington, D.C that creates livable interiors with subtle & understated palettes.
View detail page - Paul Corrie Interiors

Makres Realty Group
2816 Georgia Ave NW,
Washington, 20001
202-681-9841
Makres Realty Group is a realtor located in {City, State} and has been servicing all of Washington and the surrounding areas for many years. We specialize in {Keywords}. Here at Makres Realty Group, our mission is to always provide quality service ...
View detail page - Makres Realty Group

Sidd Kashyap Custom Home Builder
1023 Otis Place NW,
Washington D.C, 20010
571-982-6661
Save yourself from the legwork of building top-of-the-line custom homes. Contact Sidd, an accomplished general contractor, at (571) 982-6661 in Washington, DC.
View detail page - Sidd Kashyap Custom Home Builder

Leg Man USA Garage Door
717 D Street NW ,
Washington, 20004
202-779-9635
Leg Man USA offers expert garage door service to residents throughout the Washington D.C metro area. Over the years we have proven ourselves capable by helping hundreds of residents with their garage door needs. Whether we are doing repairs, ...
View detail page - Leg Man USA Garage Door